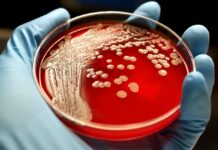
В Кара-Бууре у двух жителей выявили сибирскую язву

Внешняя политика Кыргызстана продолжает быть взвешенной, адекватной и более предсказуемой, — эксперт
Внешняя политика Кыргызстана продолжает быть взвешенной, адекватной и более предсказуемой, считает руководитель Института социально-политических исследований «Элчи», политолог Денис Бердаков.
В интервью редакции Bulak.kg эксперт выразил...
На рынке Бишкека мужчина нанес бывшей жене 16 ножевых ранений
В Бишкеке патрульная милиция задержала мужчину, который нанес 16 ножевых ранений бывшей жене на рынке.
Как сообщили в пресс-службе патрульной милиции, 16 июля...
У пассажиров рейса Москва–Бишкек грузчик из багажа украл около 21 млн рублей
Грузчик в аэропорту Шереметьево украл около 21 млн рублей из багажа двух пассажиров самолета, выполнявшего рейс Москва–Бишкек, пишет ТАСС.
«Инцидент произошел в аэропорту Шереметьево. Грузчик во время...
В Ала-Буке мужчину задержали за развратные действия в отношении 5-летней девочки
В Ала-Буке 40-летний мужчина подозревается в совершении развратных действий в отношении 5-летней девочки.
Как в пресс-службе УВД Джалал-Абадской области, 14 июля в милицию обратилась 32-летняя...
Специалист айыл окмоту пытался подкупить сотрудника ГКНБ
При попытке дачи взятки сотруднику ГКНБ КР за прекращение проверки финансово-хозяйственной деятельности был задержан главный специалист Милянфанского айыл окмоту Иссык-Атинского района.
Как сообщает пресс-служба ГКНБ,...
В Кара-Бууре у двух жителей выявили сибирскую язву
У двух жителей Кара-Бууринского района подтвердился диагноз "сибирская язва". Об этом сообщили в Министерстве здравоохранения КР.
По его данным, состояние больных удовлетворительное.
«Сотрудники центра государственного санитарно-эпидемиологического...
На Иссык-Куле 20 и 21 июля будут перекрывать дороги
20 и 21 июля по маршруту аэропорт Иссык-Куль — город Чолпон-Ата будут введены временные ограничения движения, сообщает пресс-служба ГУОБДД МВД КР.
В эти дни в...
Мэрия Бишкека объявила повторный тендер на закупку автобусов
Мэрия Бишкека объявила повторный тендер на приобретение 100 автобусов. Об этом сообщили в пресс-службе ведомства.
Отметим, 16 июня нынешнего года отечественная компания "Белес Кей Джи"...
Бывший глава ОАО «МАМ» Бакыт Шаршеев стал мэром Балыкчи
Указом президента Садыра Жапарова бывший генеральный директор ОАО "Международный аэропорт "Манас" Бакыт Шаршеев назначен мэром Балыкчи. Об этом сообщает полномочное представительство президента в Иссык-Кульской...
ГКНБ задержал кримавторитета «Доо Чынгыза»
В Бишкеке задержан ранее разыскиваемый член ОПГ «Доо Чынгыз».
Как сообщает пресс-служба Госкомитета нацбезопасности (ГКНБ) КР, член ОПГ Дж. Ч.А., известный в криминальной среде как...